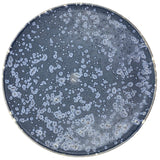

Christopher Plumridge
Christopher Plumridge, Claystone Pottery — Black Crystal Matte Dinner Plate
A beautifully unique dinner plate from Melbourne based Christopher Plumridge.
—
Christopher Plumridge is the artist behind Claystone Pottery in Highett, Victoria. His work is highly regarded for its precision, studied form and exquisite use of glazes. Originally studying in the 70s under Chinese, Japanese, English and Australian potters, his work has been featured in countless publications and his thriving practice includes commissions for the likes of Attica and the National Gallery of Australia. His outstanding work with glazes is the result of long term development of formulae he originally began testing as a student and have been refined through years of practice. This extensive research and development ensures that the colour, texture and depth remain utterly unique. His pieces are some of the last of individually made industrial quality, commercial ceramic wares to be created in Australia.
—
Material: CSIRO porcelain
Dimensions: approx. 1.5cm x 29cm
Dishwasher and microwave safe